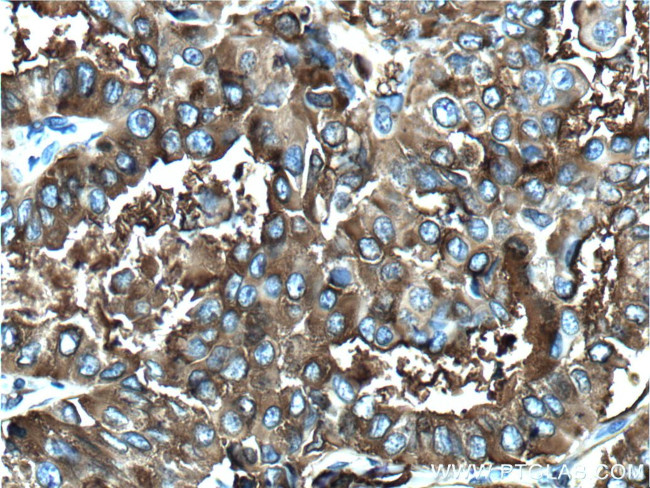
Thyroglobulin Antibody in Immunohistochemistry (Paraffin) (IHC (P))
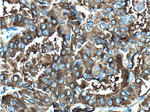
Thyroglobulin Antibody in Immunohistochemistry (Paraffin) (IHC (P))

Search
Proteintech
Thyroglobulin Monoclonal Antibody (4D3C5)
{{$productOrderCtrl.translations['antibody.pdp.commerceCard.promotion.promotions']}}
{{$productOrderCtrl.translations['antibody.pdp.commerceCard.promotion.viewpromo']}}
{{$productOrderCtrl.translations['antibody.pdp.commerceCard.promotion.promocode']}}: {{promo.promoCode}} {{promo.promoTitle}} {{promo.promoDescription}}. {{$productOrderCtrl.translations['antibody.pdp.commerceCard.promotion.learnmore']}}
产品信息
60272-1-IG
种属反应
宿主/亚型
分类
类型
克隆号
抗原
偶联物
形式
浓度
规格
纯化类型
保存液
内含物
保存条件
运输条件
产品详细信息
Immunogen sequence: AVISHERAQ QQAIALAKEV SCPMSSSQEV VSCLRQKPAN VLNDAQTKLL AVSGPFHYWG PVIDGHFLRE PPARALKRSL RVEVDLLIGS SQDDGLINRA KAVKQFEESQ GRTSSKTAFY QALQNSLGGE DSDARVEAAA TWYYSLEHST DDYASFSRAL ENATRDYFII CPIIDMASAW AKRARGNVFM YHAPENYGHG SLELLADVQF ALGLPFYPAY EGQFSLEEKS LSLKIMQYFS HFIRSGNPNY PYEFSRKVPT FATPWPDFVP RAGGENYKEF SELLPNRQGL KKADCSFWSK YISSLKTSAD GAKGGQSAES EEEELTAGSG LREDLLSLQE PGSKTYSK (2422-2768 aa encoded by BC140933)
靶标信息
The human thyroglobulin (hTg) is a high molecular weight glycoprotein (605 kDa) found in the thyroid follicular cells. It plays a central role in the uptake, incorporation, and regulated biosynthesis of thyroid hormones, T4 and T3. Thyroid disorders are, in large part, due to autoimmune origin, and anti-thyroglobulin autoantibodies were the first factor to be discovered. Anti-hTG is found in all thyroid autoimmune diseases (Hashimoto thyroiditis, Graves diseases), with the highest level observed in Hashimoto thyroiditis. Anti-hTG is also characteristic of thyroid cancer, and its determination can be used for the follow up of cancer patients.
仅用于科研。不用于诊断过程。未经明确授权不得转售。
生物信息学
蛋白别名: Colloid; Tg; Thyroglobulin; unnamed protein product
基因别名: AITD3; TG; TGN
UniProt ID: (Human) P01266
Entrez Gene ID: (Human) 7038